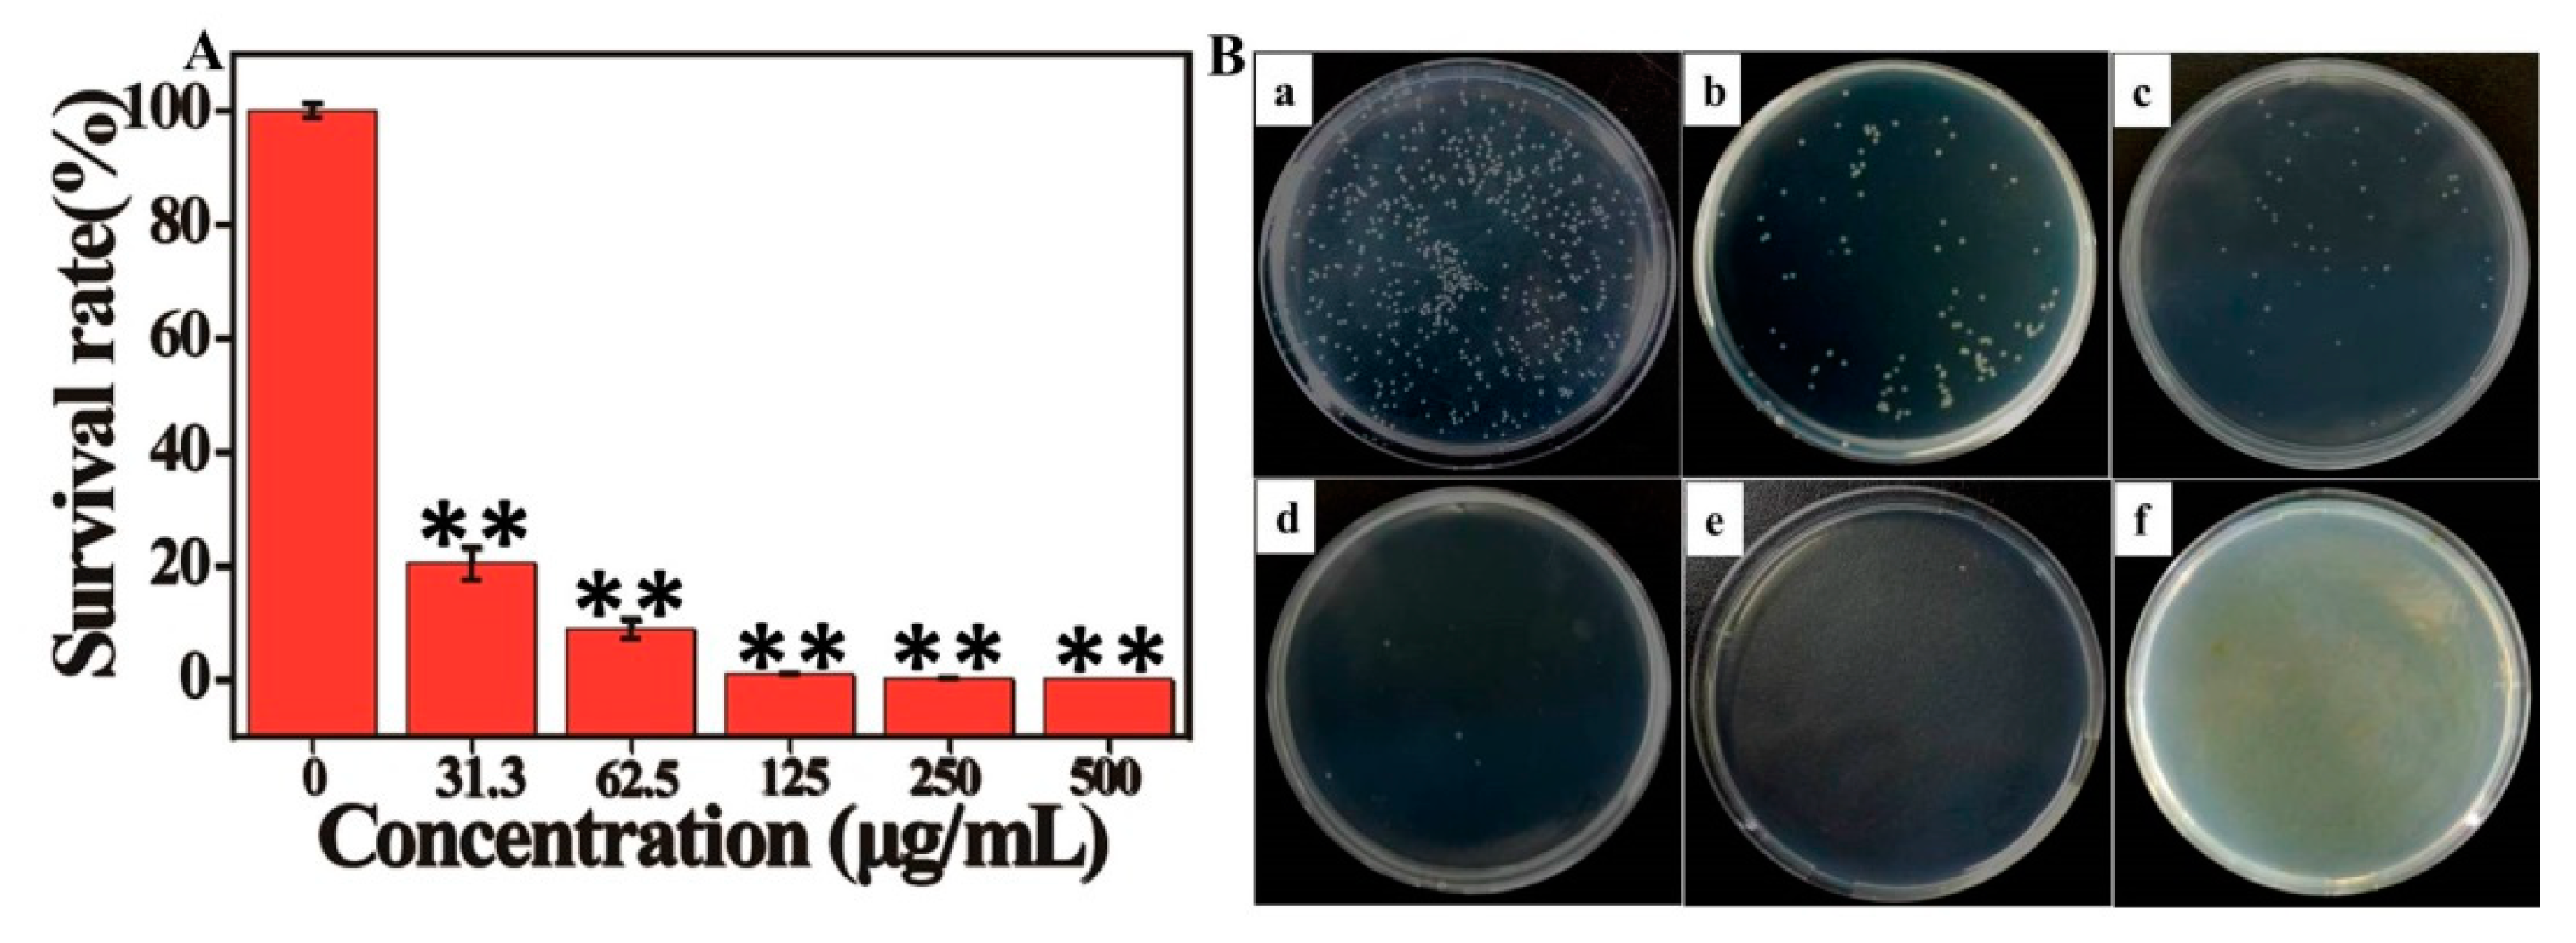
Nanomaterials 10 01545 g003

Antibacterial Activity of Manganese Dioxide Nanosheets by ROS-Mediated Pathways and Destroying Membrane Integrity
Abstract
1. Introduction
2. Materials and Methods
2.1. Reagents and Materials
2.2. Preparation of MnO2 Nanosheets
2.3. Antibacterial Assays
2.4. Live/Dead Staining Assay
2.5. Morphological Analysis of Bacterial Cells
2.6. Leakage of Intracellular Components
2.7. Measurement of Electrolyte Leakage
2.8. Reactive Oxygen Species (ROS) Assay
2.9. Analysis of Bacterial Total ATPase Activity
2.10. Cytotoxicity Assay
2.11. Statistical Analysis
3. Results and Discussion
3.1. Characterization of MnO2 Nanosheets
3.2. Antibacterial Activity of MnO2 Nanosheets
3.3. Cytotoxicity
3.4. Mechanism for Antibacterial Activity of MnO2 Nanosheets
3.4.1. Salmonella Structure Observation by TEM and SEM after Incubation with MnO2 Nanosheets
3.4.2. Generation of ROS
3.4.3. Perturbation of Membrane Integrity by MnO2 Nanosheets
4. Conclusions
Supplementary Materials
Author Contributions
Funding
Acknowledgments
Conflicts of Interest
References
- Rizzello, L.; Pompa, P.P. Nanosilver-based antibacterial drugs and devices: Mechanisms, methodological drawbacks, and guidelines. Chem. Soc. Rev. 2014, 43, 1501–1518. [Google Scholar] [CrossRef] [PubMed]
- Willyard, C. The drug-resistant bacteria that pose the greatest health threats. Nat. News 2017, 543, 15. [Google Scholar] [CrossRef] [PubMed]
- Karimi, M.; Ghasemi, A.; Zangabad, P.S.; Rahighi, R.; Basri, S.M.M.; Mirshekari, H.; Amiri, M.; Pishabad, Z.S.; Aslani, A.; Bozorgomid, M. Smart micro/nanoparticles in stimulus-responsive drug/gene delivery systems. Chem. Soc. Rev. 2016, 45, 1457–1501. [Google Scholar] [CrossRef] [PubMed]
- Huh, A.J.; Kwon, Y.J. “Nanoantibiotics”: A new paradigm for treating infectious diseases using nanomaterials in the antibiotics resistant era. J. Control. Release 2011, 156, 128–145. [Google Scholar] [CrossRef]
- Li, W.; Dong, K.; Ren, J.; Qu, X. A β-Lactamase-imprinted responsive hydrogel for the treatment of antibiotic-resistant bacteria. Angew. Chem. Int. Edit. 2016, 55, 8049–8053. [Google Scholar] [CrossRef]
- Fan, W.; Tong, X.; Farnia, F.; Yu, B.; Zhao, Y. CO2-responsive polymer single-chain nanoparticles and self-assembly for gas-tunable nanoreactors. Chem. Mater. 2017, 29, 5693–5701. [Google Scholar] [CrossRef]
- Wu, Y.; Song, Z.; Wang, H.; Han, H. Endogenous stimulus-powered antibiotic release from nanoreactors for a combination therapy of bacterial infections. Nat. Commun. 2019, 10, 1–10. [Google Scholar] [CrossRef]
- Ji, H.; Sun, H.; Qu, X. Antibacterial applications of graphene-based nanomaterials: Recent achievements and challenges. Adv. Drug Deliv. Rev. 2016, 105, 176–189. [Google Scholar] [CrossRef]
- Chen, J.; Peng, H.; Wang, X.; Shao, F.; Yuan, Z.; Han, H. Graphene oxide exhibits broad-spectrum antimicrobial activity against bacterial phytopathogens and fungal conidia by intertwining and membrane perturbation. Nanoscale 2014, 6, 1879–1889. [Google Scholar] [CrossRef]
- Song, Z.; Wu, Y.; Cao, Q.; Wang, H.; Wang, X.; Han, H. pH-responsive, light-triggered on-demand antibiotic release from functional metal-organic framework for bacterial infection combination therapy. Adv. Funct. Mater. 2018, 28, 1800011. [Google Scholar] [CrossRef]
- Wang, H.; Song, Z.; Li, S.; Wu, Y.; Han, H. One stone with two birds: Functional gold nanostar for targeted combination therapy of drug-resistant staphylococcus aureus infection. ACS Appl. Mater. Interfaces 2019, 11, 32659–32669. [Google Scholar] [CrossRef] [PubMed]
- Li, X.; Robinson, S.M.; Gupta, A.; Saha, K.; Jiang, Z.; Moyano, D.F.; Sahar, A.; Riley, M.A.; Rotello, V.M. Functional gold nanoparticles as potent antimicrobial agents against multi-drug-resistant bacteria. ACS Nano 2014, 8, 10682–10686. [Google Scholar] [CrossRef] [PubMed]
- Yang, X.; Makita, Y.; Liu, Z.H.; Sakane, K.; Ooi, K. Structural characterization of self-assembled MnO2 nanosheets from birnessite manganese oxide single crystals. Chem. Mater. 2004, 16, 5581–5588. [Google Scholar] [CrossRef]
- Chen, Y.; Ye, D.; Wu, M.; Chen, H.; Zhang, L.; Shi, J.; Wang, L. Break-up of two-dimensional MnO2 nanosheets promotes ultrasensitive pH-triggered theranostics of cancer. Adv. Mater. 2014, 26, 7019–7026. [Google Scholar] [CrossRef] [PubMed]
- Zeng, D.; Wang, L.; Tian, L.; Zhao, S.; Zhang, X.; Li, H. Synergistic photothermal/photodynamic suppression of prostatic carcinoma by targeted biodegradable MnO2 nanosheets. Drug Deliv. 2019, 26, 661–672. [Google Scholar] [CrossRef] [PubMed]
- Liu, Z.; Zhang, S.; Lin, H.; Zhao, M.; Yao, H.; Zhang, L.; Peng, W.; Chen, Y. Theranostic 2D ultrathin MnO2 nanosheets with fast responsibility to endogenous tumor microenvironment and exogenous NIR irradiation. Biomaterials 2018, 155, 54–63. [Google Scholar] [CrossRef] [PubMed]
- Chen, J.; Meng, H.; Tian, Y.; Yang, R.; Du, D.; Li, Z.; Qu, L.; Lin, Y. Recent advances in functionalized MnO2 nanosheets for biosensing and biomedicine applications. Nanoscale Horiz. 2019, 4, 321–338. [Google Scholar] [CrossRef]
- Chu, K.; Liu, Y.Q.; Cheng, Y.H.; Li, Q.Q. Synergistic boron-dopants and boron-induced oxygen vacancies in MnO2 nanosheets to promote electrocatalytic nitrogen reduction. J. Mater. Chem. A 2020, 8, 5200. [Google Scholar] [CrossRef]
- Li, G.L.; Xia, Y.H.; Li, Q. Biodegradable MnO2 nanosheet-mediated catalytic hairpin assembly for two-color imaging of mRNAs in living cells. Microchem. J. 2020, 153, 104367. [Google Scholar] [CrossRef]
- Chen, Y.; Cong, H.; Shen, Y.; Yu, B. Biomedical application of manganese dioxide nanomaterials. Nanotechnology 2020, 31, 202001. [Google Scholar] [CrossRef]
- Fan, H.; Yan, G.; Zhao, Z.; Hu, X.; Zhang, W.; Liu, H.; Fu, X.; Fu, T.; Zhang, X.B.; Tan, W. A smart photosensitizer-manganese dioxide nanosystem for enhanced photodynamic therapy by reducing glutathione levels in cancer cells. Angew. Chem. Int. Edit. 2016, 55, 5477–5482. [Google Scholar] [CrossRef] [PubMed]
- Fan, H.; Zhao, Z.; Yan, G.; Zhang, X.; Yang, C.; Meng, H.; Chen, Z.; Liu, H.; Tan, W. A smart DNAzyme-MnO2 nanosystem for efficient gene silencing. Angew. Chem. Int. Edit. 2015, 54, 4801–4805. [Google Scholar] [CrossRef] [PubMed]
- Zhao, Z.; Fan, H.; Zhou, G.; Bai, H.; Liang, H.; Wang, R.; Zhang, X.; Tan, W. Activatable fluorescence/MRI bimodal platform for tumor cell imaging via MnO2 nanosheet-aptamer nanoprobe. J. Am. Chem. Soc. 2014, 136, 11220–11223. [Google Scholar] [CrossRef]
- Zhang, J.; Xu, M.; Mu, Y.; Li, J.; Foda, M.F.; Zhang, W.; Han, K.; Han, H. Reasonably retard O2 consumption through a photoactivity conversion nanocomposite for oxygenated photodynamic therapy. Biomaterials 2019, 218, 119312. [Google Scholar] [CrossRef]
- Steel, C.C.; Drysdale, R.B. Electrolyte leakage from plant and fungal tissues and disruption of liposome membranes by α-tomatine. Phytochemistry 1988, 27, 1025–1030. [Google Scholar] [CrossRef]
- Du, T.; Liang, J.; Dong, N.; Lu, J.; Fu, Y.; Fang, L.; Xiao, S.; Han, H. Glutathione-capped Ag2S nanoclusters inhibit coronavirus proliferation through blockage of viral RNA synthesis and budding. ACS Appl. Mater. Interfaces 2018, 10, 4369–4378. [Google Scholar] [CrossRef] [PubMed]
- Deng, R.; Xie, X.; Vendrell, M.; Chang, Y.T.; Liu, X. Intracellular glutathione detection using MnO2-nanosheet-modified upconversion nanoparticles. J. Am. Chem. Soc. 2011, 133, 20168–20171. [Google Scholar] [CrossRef] [PubMed]
- Butmee, P.; Tumcharern, G.; Thouand, G.; Kalcher, K.; Samphao, A. An ultrasensitive immunosensor based on manganese dioxide-graphene nanoplatelets and core shell Fe3O4@Au nanoparticles for label-free detection of carcinoembryonic antigen. Bioelectrochemistry 2020, 132, 107452. [Google Scholar] [CrossRef] [PubMed]
- Chu, C.; Lin, H.; Liu, H.; Wang, X.; Wang, J.; Zhang, P.; Gao, H.; Huang, C.; Zeng, Y.; Tan, Y. Tumor microenvironment-triggered supramolecular system as an in situ nanotheranostic generator for cancer phototherapy. Adv. Mater. 2017, 29, 1605928. [Google Scholar] [CrossRef]
- Yang, Q.; Wang, X.; Peng, H.; Arabi, M.; Li, J.; Xiong, H.; Choo, J.; Chen, L. Ratiometric fluorescence and colorimetry dual-mode assay based on manganese dioxide nanosheets for visual detection of alkaline phosphatase activity. Sens. Actuat. B Chem. 2020, 302, 127176. [Google Scholar] [CrossRef]
- Parveen, N.; Ansari, S.A.; Ansari, M.O.; Cho, M.H. Manganese dioxide nanorods intercalated reduced graphene oxide nanocomposite toward high performance electrochemical supercapacitive electrode materials. Colloid Interface Sci. 2017, 506, 613–619. [Google Scholar] [CrossRef] [PubMed]
- Fan, W.; Bu, W.; Shen, B.; He, Q.; Cui, Z.; Liu, Y.; Zheng, X.; Zhao, K.; Shi, J. Intelligent MnO2 nanosheets anchored with upconversion nanoprobes for concurrent pH-/H2O2-responsive UCL imaging and oxygen-elevated synergetic therapy. Adv. Mater. 2015, 27, 4155–4161. [Google Scholar] [CrossRef] [PubMed]
- Mao, C.; Xiang, Y.; Liu, X.; Zheng, Y.; Yeung, K.W.K.; Cui, Z.; Yang, X.; Li, Z.; Liang, Y.; Zhu, S. Local photothermal/photodynamic synergistic therapy by disrupting bacterial membrane to accelerate reactive oxygen species permeation and protein leakage. ACS Appl. Mater. Interfaces 2019, 11, 17902–17914. [Google Scholar] [CrossRef] [PubMed]
- Shang, B.; Xu, M.; Zhi, Z.; Xi, Y.; Deng, Z. Synthesis of sandwich-structured silver@polydopamine@silver shells with enhanced antibacterial activities. J. Colloid Interface Sci. 2020, 558, 47–54. [Google Scholar] [CrossRef] [PubMed]
- Liu, C.; Shan, H.; Chen, X.; Si, Y.; Ding, B. Novel inorganic-based N-halamine nanofibrous membranes as highly effective antibacterial agent for water disinfection. ACS Appl. Mater. Interfaces 2018, 10, 44209–44215. [Google Scholar] [CrossRef]
- Xi, J.; Wei, G.; An, L.; Xu, Z.; Gao, L. Copper/carbon hybrid nanozyme: Tuning catalytic activity by copper state for antibacterial therapy. Nano Lett. 2019, 19, 7645–7654. [Google Scholar] [CrossRef]
- Zheng, H.; Ji, Z.; Roy, K.R.; Gao, M.; Li, R. Engineered graphene oxide nanocomposite capable of preventing the evolution of antimicrobial resistance. ACS Nano 2019, 13, 11488–11499. [Google Scholar] [CrossRef]
- Hu, C.; Zhang, F.J.; Kong, Q.S.; Lu, Y.H.; Zhang, B.; Wu, C.; Luo, R.F.; Wang, Y.B. Synergistic chemical and photodynamic antimicrobial therapy for enhanced wound healing mediated by multifunctional light-responsive nanoparticles. Biomacromolecules 2019, 20, 4581–4592. [Google Scholar] [CrossRef]
- Li, X.S.; Bai, H.T.; Yang, Y.C.; Yoon, J.Y.; Wang, S.; Zhang, X. Supramolecular antibacterial materials for combatting antibiotic resistance. Adv. Mater. 2019, 31, 1805092. [Google Scholar] [CrossRef]
- Ding, X.; Duan, S.; Ding, X.; Liu, R.; Xu, F.J. Versatile antibacterial materials: An emerging arsenal for combatting bacterial pathogens. Adv. Funct. Mater. 2018, 28, 1802140. [Google Scholar] [CrossRef]
- Sun, L.; Du, T.; Hu, C.; Chen, J.; Lu, J.; Lu, Z.; Han, H. Antibacterial activity of graphene oxide/g-C3N4 composite through photocatalytic disinfection under visible light. ACS Sustain. Chem. Eng. 2017, 5, 8693–8701. [Google Scholar] [CrossRef]
- Wang, Y.W.; Tang, H.; Wu, D.; Liu, D.; Liu, Y.; Cao, A.; Wang, H. Enhanced bactericidal toxicity of silver nanoparticles by the antibiotic gentamicin. Environ. Sci. Nano 2016, 3, 788–798. [Google Scholar] [CrossRef]
- Hou, W.C.; Lee, P.L.; Chou, Y.C.; Wang, Y.S. Antibacterial property of graphene oxide: The role of phototransformation. Environ. Sci. Nano 2017, 4, 647–657. [Google Scholar] [CrossRef]
- Chen, H.; Wang, B.; Gao, D.; Guan, M.; Zheng, L.; Ouyang, H.; Chai, Z.; Zhao, Y.; Feng, W. Broad-spectrum antibacterial activity of carbon nanotubes to human gut bacteria. Small 2013, 9, 2735–2746. [Google Scholar] [CrossRef] [PubMed]
- Li, X.; Shi, Y.; Miao, B.; Zhao, Y. Effects of embedded carbon nanotube on properties of biomembrane. J. Phys. Chem. B 2012, 116, 5391–5397. [Google Scholar] [CrossRef]
- AshaRani, P.V.; Mun, G.L.K.; Hande, M.P.; Valiyaveettil, S. Cytotoxicity and genotoxicity of silver nanoparticles in human cells. ACS Nano 2009, 3, 279–290. [Google Scholar] [CrossRef]
- Song, Z.; Wu, Y.; Wang, H.; Han, H. Synergistic antibacterial effects of curcumin modified silver nanoparticles through ROS-mediated pathways. Mater. Sci. Eng. C 2019, 99, 255–263. [Google Scholar] [CrossRef]
- Song, Z.; Wang, H.; Wu, Y.; Gu, J.; Li, S.; Han, H. Fabrication of bis-quaternary ammonium salt as an efficient bactericidal weapon against Escherichia coli and Staphylococcus aureus. ACS Omega 2018, 3, 14517–14525. [Google Scholar] [CrossRef]

© 2020 by the authors. Licensee MDPI, Basel, Switzerland. This article is an open access article distributed under the terms and conditions of the Creative Commons Attribution (CC BY) license (http://creativecommons.org/licenses/by/4.0/).
Share and Cite
Du, T.; Chen, S.; Zhang, J.; Li, T.; Li, P.; Liu, J.; Du, X.; Wang, S. Antibacterial Activity of Manganese Dioxide Nanosheets by ROS-Mediated Pathways and Destroying Membrane Integrity. Nanomaterials 2020, 10, 1545. https://doi.org/10.3390/nano10081545
Du T, Chen S, Zhang J, Li T, Li P, Liu J, Du X, Wang S. Antibacterial Activity of Manganese Dioxide Nanosheets by ROS-Mediated Pathways and Destroying Membrane Integrity. Nanomaterials. 2020; 10(8):1545. https://doi.org/10.3390/nano10081545
Chicago/Turabian StyleDu, Ting, Siya Chen, Jinyu Zhang, Tingting Li, Ping Li, Jifeng Liu, Xinjun Du, and Shuo Wang. 2020. "Antibacterial Activity of Manganese Dioxide Nanosheets by ROS-Mediated Pathways and Destroying Membrane Integrity" Nanomaterials 10, no. 8: 1545. https://doi.org/10.3390/nano10081545
APA StyleDu, T., Chen, S., Zhang, J., Li, T., Li, P., Liu, J., Du, X., & Wang, S. (2020). Antibacterial Activity of Manganese Dioxide Nanosheets by ROS-Mediated Pathways and Destroying Membrane Integrity. Nanomaterials, 10(8), 1545. https://doi.org/10.3390/nano10081545

